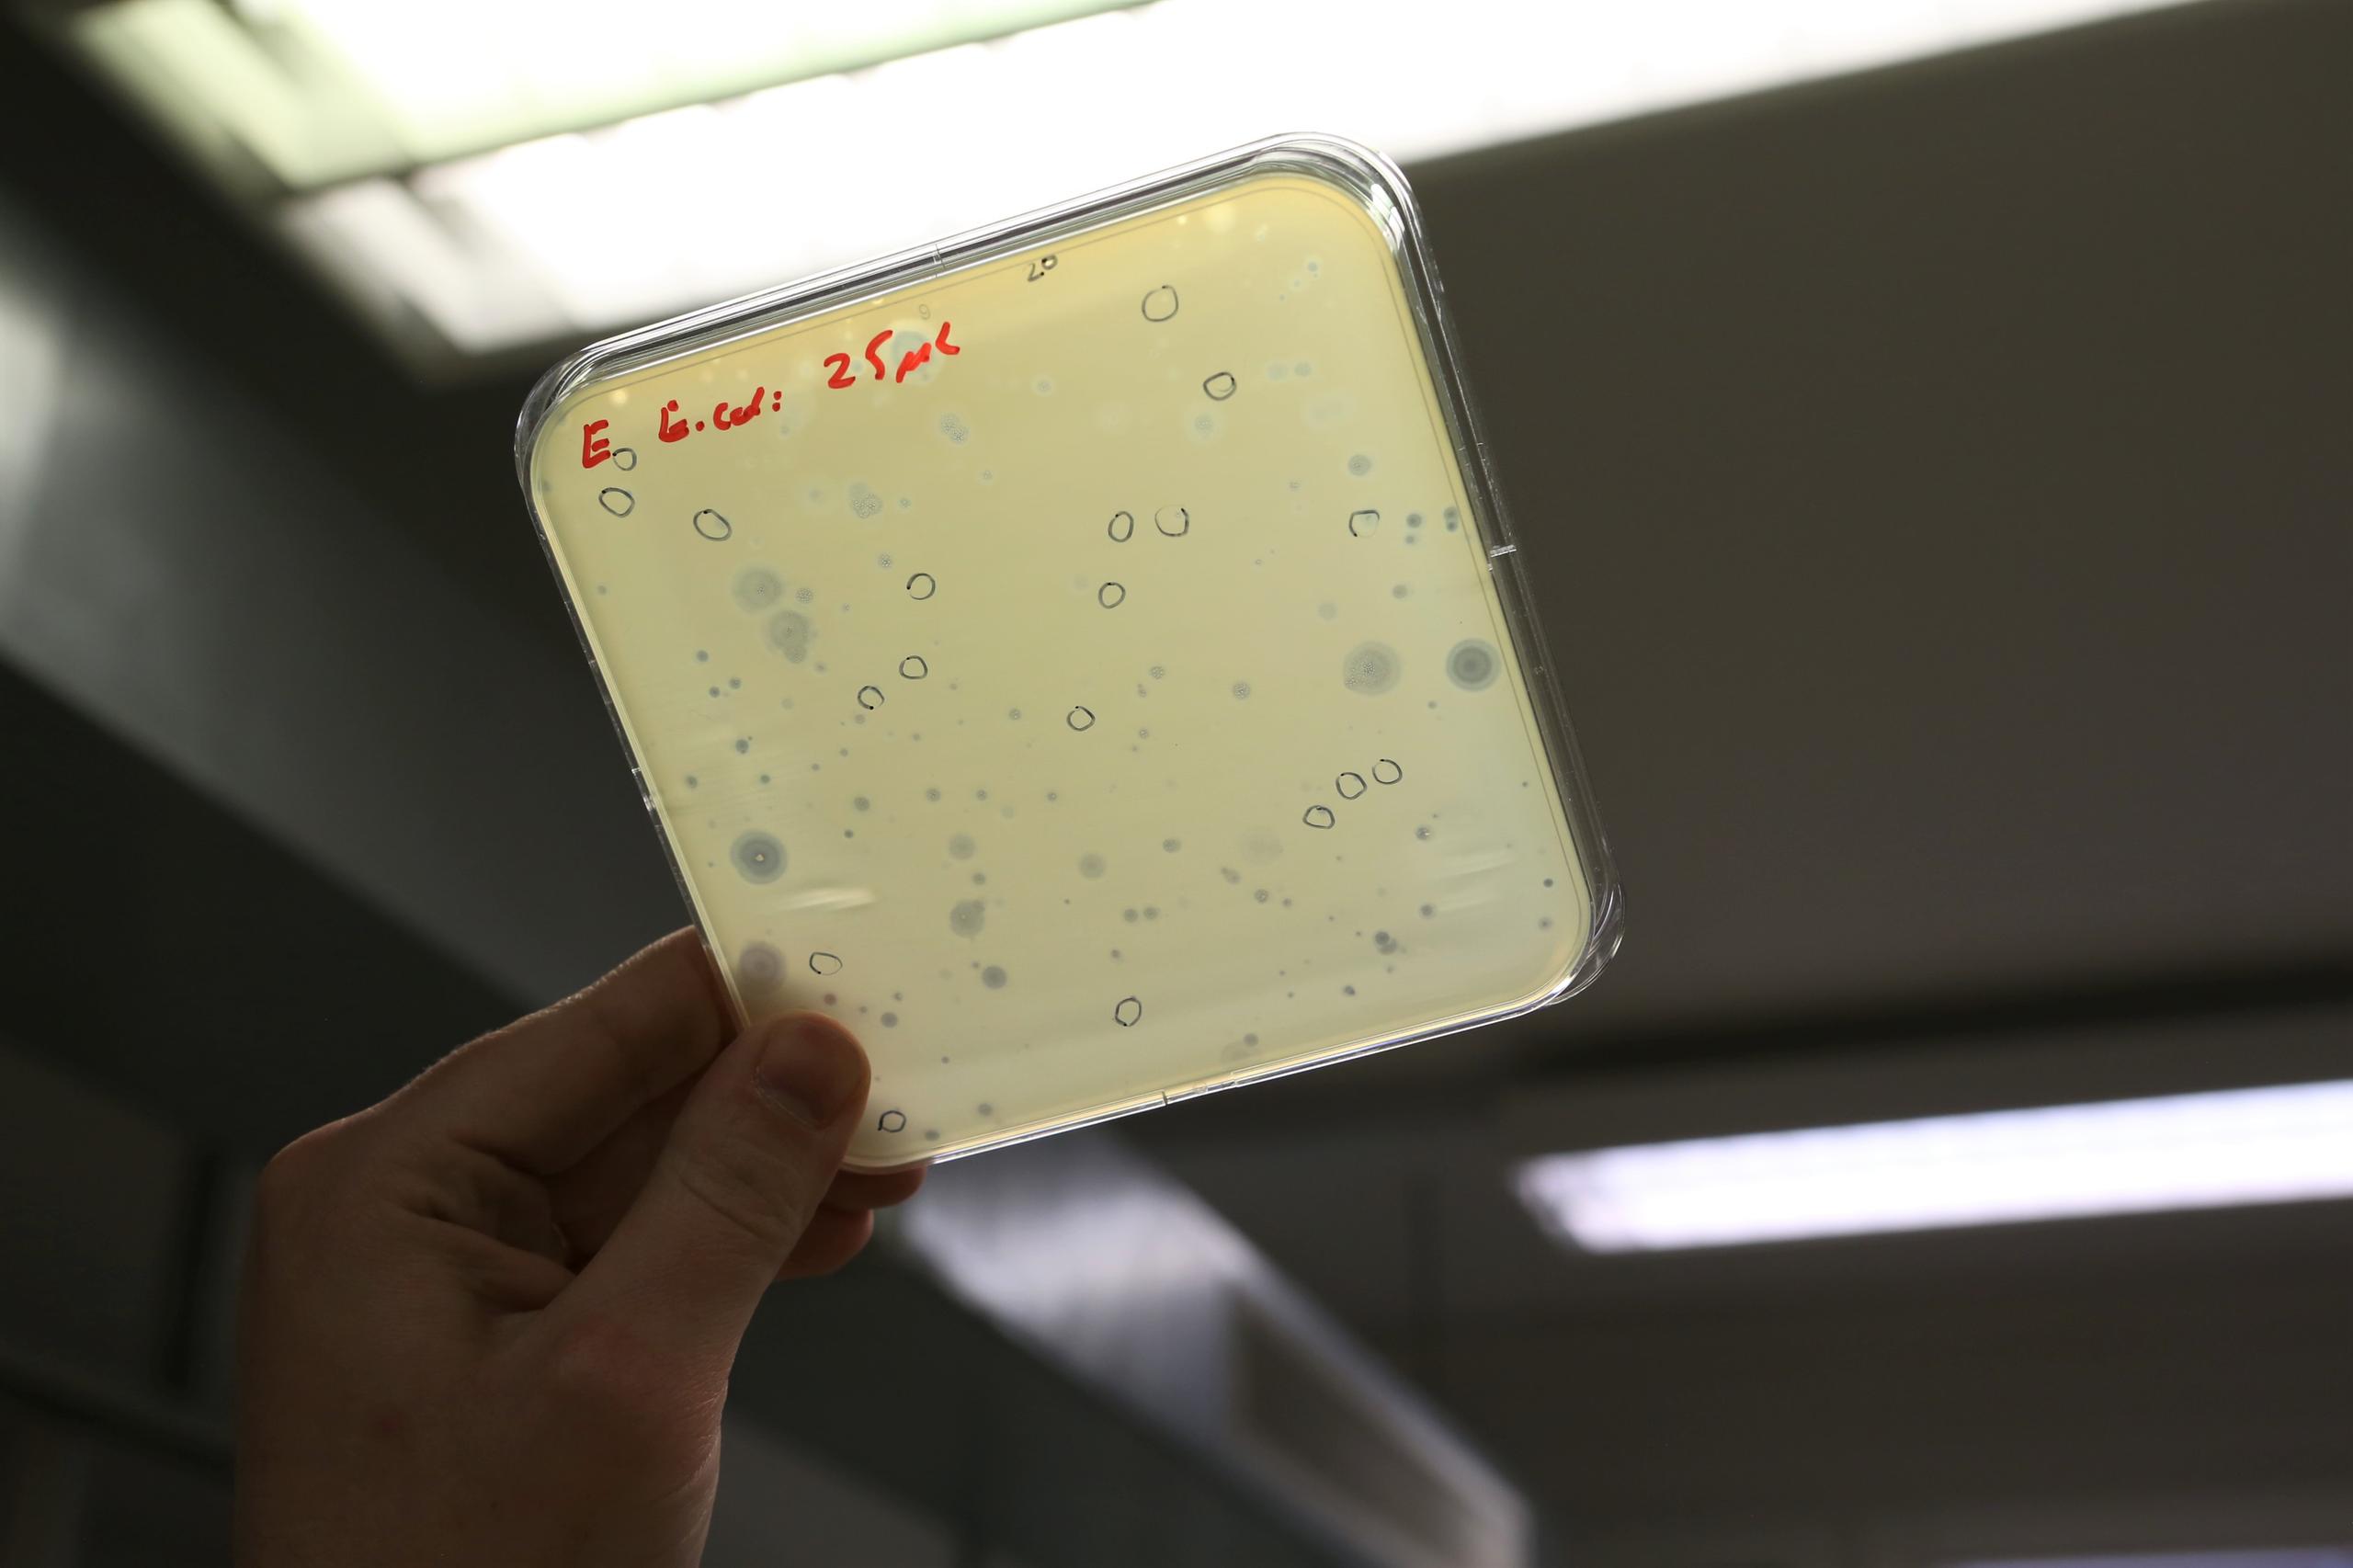

علاج للبكتيريا الضارَّة يكمن في مياه نهر الراين

يُشكِّل تزايد مقاومة البكتيريا للمضادات الحيوية خطراً متفاقماً يهدد الصحة العامة في جميع أرجاء العالم. وفي سويسرا، يجري العمل الآن على جمع ودراسة مجموعة من الفيروسات النافعة (تعرف باسم العاثيات) لمُساعدة الباحثين حول العالم على تطوير علاجات جديدة للأمراض البكتيرية المستعصية.
لم يمض زمن طويل على خروج العالم من الأزمة التي سبَّبتها جائحة كوفيد-19. وفي هذا التوقيت، قد يبدو الحديث عن فيروسات “نافعة” مفارقةً غريبةً. ويجدر القول في هذا المقام، أن الفيروسات ليست كلها ضارَّة بصحة البشر. فالعاثيات هي نوع من الفيروسات يتطفَّل على البكتيريا ليتكاثر داخلها فيقضي عليها.
ويرى ألكساندر هارمس، عالم الأحياء الدقيقة، أنَّ هذا النوع من الفيروسات قد أثبت أنَّ له فائدة كبيرة للبشر وأنَّه قادر على إنقاذ الكثير من الأرواح. ويستدرك قائلاً إنَّ “دراستها [أي العاثيات] أشبه ما تكون باستكشاف الجانب البعيد من القمر”، وذلك بسبب قلة المعلومات والمعارف بشأنها.
وفي عام 2019 ولزيادة المعارف عن هذه الفيروسات، انبرت مجموعة من طلبة المرحلة الثانوية في مدينة بازل، شمال غرب سويسرا، على جمع عينات من موائلها في الطبيعة، وأجروا عليها دراسات لتحديد خصائصها. واليوم، باتت هذه الفيروسات مصدراً هاماً للمؤسسات البحثية من مختلف أرجاء العالم، ويؤمل أن تُستخدم يوماً ما كعلاج للعدوى البكتيرية.

قاتلات البكتيريا
كسائر أنواع الفيروسات، لا تستطيع العاثيات التكاثر إلا في جسم العائِلِ، فتغزو البكتيريا وتتطفل على جهازها الأيضي لتتكاثر داخلها. وبعد إتمام عملية التكاثر، تخرج العاثيات الجديدة من البكتيريا العائلةِ مسببة تمزُّق (أو تحلُّل) خلاياها، ومن ثمَّ موتها.
وتعيش العاثيات بأعداد تبلغ المليارات على امتداد النظم الحيوية في كوكب الأرض؛ من أرضيات الغابات إلى أسطح المحيطات، ولها دور حيوي في دورة الكربون. فعلى سبيل المثال، لدى العاثيات القدرة على تحليل البكتيريا البحرية ونشر ما تحتزنه من مغذيات في مياه المحيط. وعن هذا الدور الحيوي الذي تؤديه العاثيات يقول هارمس: “إنَّها من بين القوة الأساسية لاستمرار الحياة على كوكبنا”. وكان هارمس يعمل، حتى العام الماضي، لدى مركز الدراسات البيولوجية “Biozentrumرابط خارجي” التابع لجامعة بازل، وهو مركز متخصص في البحوث الجزيئية والبحوث الطبية الحيوية الأساسية.
وتعيش العاثيات أيضاً في أجسامنا، ولكنها لا تهاجم الخلايا البشرية، ويقتصر تأثيرها على تركيبة المجموعات البكتيرية في أجسامنا. وما تزال المعلومات التي توضِّح تأثيرها في الأحياء الدقيقة المعويةرابط خارجي قليلة جدًّا.
>> من أجل فهم أفضل لدورة حياة العاثيات، يُمكن مشاهدة مقطع الفيديو التالي (بالانجليزية):
ويرى هارمس أنَّ العاثيات من الأدوات البحثية التي لها أهمية كبيرة، وذلك بفضل قدرتها على انتقاء أنواع البكتيريا التي تغزوها، فهي قادرة على تمييز أنواع محددة من البكتيريا، وغالباً ما يقتصر هجومها على سلالات محددة من هذه الأنواع البكتيرية. ويمكن الاستفادة من العاثيات في القضاء على بعض أنواع البكتيريا التي تسبب تلوّث الأغذية، كالسلمونيلا، أو في علاج الالتهابات البكتيرية التي تصيب الأجهزة البولية والتنفسية.
وينصبُّ اهتمام هارمس على العاثيات التي تهاجم “البكتيريا النائمة” أو “الصوامد” وهي بكتيريا تسبب التهابات مزمنة وتتميز بقدرتها على مقاومة المضادات الحيوية عن طريق الذهاب في سبات عميق إلى حين زوال أثر المضاد الحيوي. ومن أجل دراسة هذا النوع من العاثيات، يتجهَّز هارمس بعدَّته من أنابيب اختبار وينطلق إلى الطبيعة ليجمع عينات منها.
نوع جديد من العاثيات في مياه نهار الراين
في صيف عام 2019 وفي إطار دورة دراسية يُنظمها مركز الدراسات البيولوجية تحت اسم “أكاديمية بازل الصيفية للعلوم”، انطلق هارمس ومجموعة من طلبة المرحلة الثانوية في أرجاء مدينة بازل وما حولها، ليجمعوا عينات من مياه نهر الراين وتربته، ومن برك الحدائق، وصناديق المخلفات النباتية، ومحطات معالجة مياه الصرف الصحي. ويتذكَّر هارمس تلك الجهود قائلاً: “لم ندر آنذاك ما نحن مقبلون على اكتشافه”.

وبعد سنتين، نُشرت مجريات الدراسة ونتائجها في المجلة الدورية العلمية “PLOS Biologyرابط خارجي“. وباختصار، كان الهدف منها تعريض سلاسلات من بكتيريا الإشريكية القولونية لمجموعة ضمَّت 70 نوعاً من العاثيات، ودراسة تأثير العاثيات على هذا النوع من البكتيريا التي يُمكن أن تسبب أمراضاً خطيرة وهي واحدة من أكثر أنواع البكتيريا المعوية انتشاراً.
أمَّا عن نتائج الدراسة، فقد أثبتت أن المجموعات المتشابهة من العاثيات تتشابه أيضاً في وظائفها على اختلاف مواقعها في أرجاء العالم. ويقول هارمس “كانت هذه النتيجة مفاجئة بالنسبة لي”، ويضيف أن الدراسة كشفت عن نتيجة هي الأكثر أهمية، إذ أظهرت أن مجموعة متنوعة من العاثيات قادرة على مهاجمة بكتيريا الإشريكية القولونية. ويذكر هارمس أنَّ مجموعات أكبررابط خارجي تضم المئات من العاثيات سبق تحديدها في بلدان وأماكن أخرى، إلا أن هذه المجموعات لا تتبع منهجية منتظمة في تحديد خصائص العاثيات كما هو الحال في مجموعة بازل.
ومن المنتظر الآن أن تكون مجموعة بازل مفيدة أيضاً في البحوث التي تُجرى خارج حدود سويسرا والتي تهدف إلى استخدام العاثيات كبديل للمضادات الحيوية في معالجة العدوى البكتيرية. فعلى سبيل المثال، أظهرت العاثيات فاعليتهارابط خارجي في القضاء على البكتيريا التي تُسبّب قروحاً وجروحاً مزمنة لدى مرضى السكري، والتي غالباً ما تستلزم بتر الأطراف المصابة.
عودة العاثيات إلى الساحة الطبية
ظهرت فكرة استخدام العاثيات كعلاج طبي في أوائل القرن العشرين، وتحديداً في المنطقة التي كانت تُعرف باسم الاتحاد السوفياتي. وكان العلاج بالعاثيات آنذاك يُعطى على شكل حقن وريدية أو عن طريق بخاخات. وفي أثناء الحرب العالمية الثانية، استُخدمت العاثيات لمعالجة الجنود المصابين بالدوسنتاريا، وهو التهاب معوي يُسبّب الإسهال الدموي. ولكن الجهود البحثية التي تدرس العاثيات، وخصوصاً في دول العالم الغربي، شهدت تراجعاً بسبب اكتشاف المضادات الحيوية وانتشار استخدامها، وكان البنسلين الذي اكتُشف في عام 1929 هو أول مضاد حيوي عرفه العالم.
ومع تزايد مقاومة البكتيريا للمضادات الحيوية في جميع أرجاء العالم، أصبح علاج بعض أمراض العدوى البكتيرية، مثل الالتهاب الرئوي والتدرن الرئوي، يزداد صعوبة يوماً بعد يوم. ووفقاً لدراسةرابط خارجي نُشرت في عام 2022، تسببت مقاومة المضادات الحيوية في عام 2019 بأكثر من 1.2 مليون حالة وفاة في العالم، وهو عدد يفوق ما يسببه فيروس العوز المناعي البشري أو الملاريا. ويُحتمل أن يرتفع هذا العدد ليصل إلى 10 ملايين حالة وفاة سنوياًرابط خارجي بحلول عام 2025.
وتعدُّ منظمة الصحة العالمية مقاومة المضادات الحيوية من بين أكبر المخاطررابط خارجي التي تحيق اليوم بالصحة العالمية، وتكثِّف دول العالم الغربي جهودها البحثية لدراسة العلاج بالعاثيات، بالنظر إلى قلة الأعراض الجانبية التي تحدثها وقلة المخاطر التي تنطوي عليها.
متطلبات التصريح بالاستخدام العلاجي
يقول هارمس إن العاثيات النافعة رغم كثرة الحديث عنها، إلا أن استخداماتها العلاجية لا تزال غير واسعة الانتشار. وذلك لأنها تنطوي على عملية معقدة ومُكلِفة، فيجب أولاً تحديد البكتيريا المسؤولة عن مرض معين ودراسة خصائصها، ومن ثمَّ يجب البحث عن العاثية المناسبة للقضاء على تلك البكتيريا. وكذلك، قد تتعرض العاثيات لهجوم من الجهاز المناعي في جسم الإنسان. كما أن استخدامها المتكرر قد يجعل البكتيريا مقاومة لها أيضاً، كما هو الحال في المضادات الحيوية.
ومن أسباب عدم الانتشار الواسع للعلاج بالعاثيات أنَّ طفرات قد تطرأ عليها فتغيّر من تركيبتها المعقدة أصلاً، وذلك على عكس المضادات الحيوية التي لها خصائص وتراكيب محددة ومستقرَّة يُمكن تكرارها. ولهذا السبب، يصعب الحصول على تصريح باستخدام العاثيات استخداماً علاجياً. ويقول لوكاس ياغي، المتحدث باسم الهيئة السويسرية لترخيص ومراقبة المُنتجات العلاجية (Swissmedic) إنَّ العاثيات “من أجل استخدامها استخدامات علاجية، يجب أن يجري تحضيرها بطريقة تلبي المتطلبات التي تسري على سائر العقاقير العلاجية الأخرى”.
ويضيف ياغي أنه “ولغاية الآن، لم يصدر في سويسرا تصريح لمثل عملية التحضير هذه. إلا أنه في عام 2015، أجريت [في سويسرا] تجربة سريريةرابط خارجي، ولا يُمكن نفي وجود بعض الحالات المنفردة التي استخدم فيها بعض الأطباء علاجات بالعاثيات أحضروها من خارج سويسرا لعلاج بعض الأمراض”.
من الراين إلى أستراليا
وبالعودة إلى حديثنا مع هارمس، الذي يعمل الآن في المعهد التقني الفدرالي العالي بزيورخ، فقد أعرب عن أمله بأن تكون مجموعة بازل دافعاً يحثُّ على إجراء المزيد من الأبحاث لاستخدام العاثيات كعلاجات فعالة. ويرى هارمس أن فوائد العاثيات لا تنحصر في مجال الطبِّ البشري فحسب، بل “يُمكن أن تكون مفيدة في مكافحة البكتيريا التي تدمر المحاصيل الزراعية”. فمثلاً، يمكن رش مستحضرات العاثيات على كروم الزيتون المصابة ببكتيريا زيليلا “Xylella fastidiosa”، وهي بكتيريا تدمر آلاف أشجار الزيتون في منطقة بوليا (Puglia) بإيطاليا، أو في مزارع التفاح والكمثرى المصابة باللفحات النارية البكيترية في سويسرا.
ولغاية الآن، طلب أكثر من 40 مختبراً حول العالم عاثيات من المجموعة السويسرية. ولأن نتائج الدراسات التي أجرتها هذه المختبرات لم تُنشر بعد، فإن هارمس لا يدري إن كانت هذه العاثيات قد ساهمت بالفعل في إنقاذ أرواح بشرية أو محاصيل زراعية أم لا.
ولكنه يقول إن شعوراً خاصاً ينتابه عند مجرد التفكير في أنَّ العاثيات التي جمعها من نهر الراين في بازل، بأقلِّ التكاليف المالية، تُستخدم الآن في مشاريع البحوث في قارات وبلدان بعيدة مثل أستراليا والولايات المتحدة.
ويضيف “أريد أن أشارك مجموعتنا من العاثيات مع الأفراد المهتمين في كل مكان في العالم. فالبالمشاركة يُثمر العلم”.
تحرير: صابرينا فايس
ترجمة: ريم حسونه

متوافق مع معايير الصحافة الموثوقة
المزيد: SWI swissinfo.ch تحصل على الاعتماد من طرف "مبادرة الثقة في الصحافة"
























يمكنك العثور على نظرة عامة على المناقشات الجارية مع صحفيينا هنا . ارجو أن تنضم الينا!
إذا كنت ترغب في بدء محادثة حول موضوع أثير في هذه المقالة أو تريد الإبلاغ عن أخطاء واقعية ، راسلنا عبر البريد الإلكتروني على arabic@swissinfo.ch.